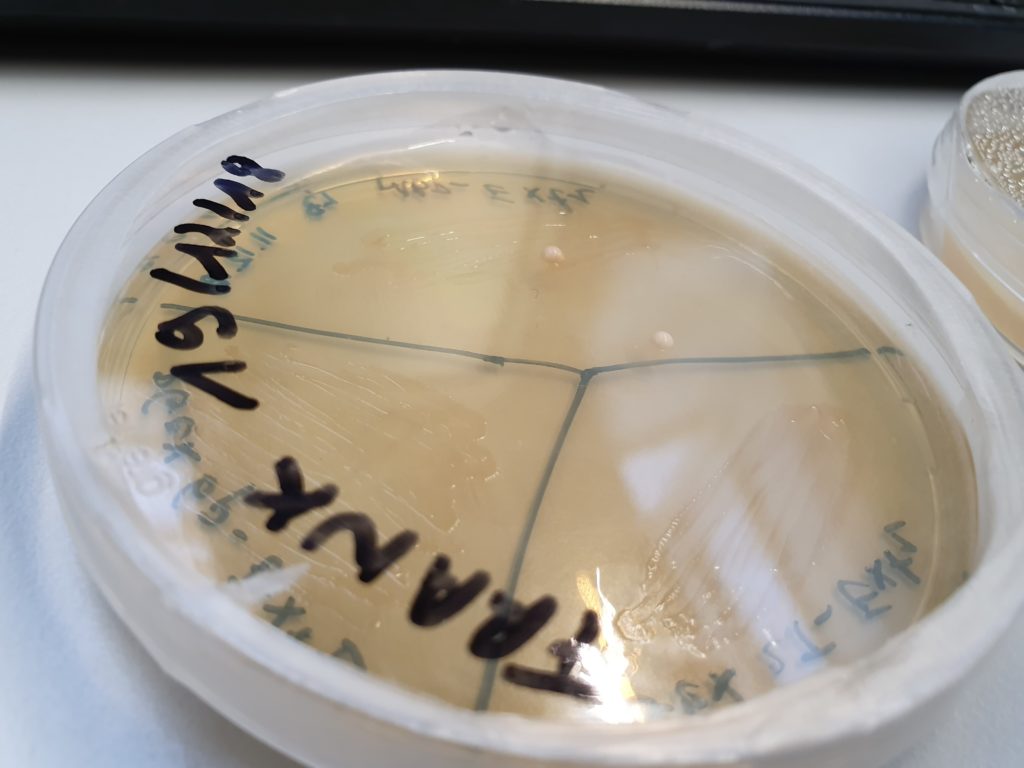

La réactivation d’une levure⎜Pour les Nuls
Suite à l’analyse de la bouteille de la Veille Saison Colmant (de 40 ans d’âge !), les plus curieux d’entre vous retrouveront dans cet article une explication simplifiée du processus de réactivation d’une levure. Place à la ZythoClass !
Imaginons que vous retrouvez une vieille bouteille de bière dans votre cave et que vous possédez un laboratoire ultra moderne. Ou que vous réussissez à vous incruster dans un laboratoire universitaire.

Comment procède-t-on ?
Le processus que les techniciens de Gembloux AgroBio Tech ont suivi pour récupérer la levure de la Vieille Saison Colmant est assez « simple » :
- Ils ont ouvert la bouteille ;
- Récupéré le contenu ;
- Dégazé la bière ;
- Et ils ont mis un échantillon dans un pot de centrifugation.
- Le dépôt qui se forme après cette manoeuvre (ou le « culot », ou encore le « précipité ») (pour utiliser les bons termes scientifiques) est récupéré pour les différents tests.
- Ils prélèvent un échantillon par test, le reste est conservé dans du glycérol dans un frigo à -80°C (glaglagla).
Vous suivez toujours ?

Ils ont ensuivi effectué 2 types de tests : dans une fiole et dans une boîte.
L’épreuve de la fiole
La fiole contient un liquide appelé « milieu stérile » (c’est-à-dire un extrait de malt stérilisé), dans lequel la levure récupérée pourra se multiplier. L’objectif est d’y inoculer l’échantillon de précipité.
Pour éviter toute contamination, la manipulation est réalisée sous une hotte à flux d’air continu (qui permet de séparer l’air intérieur et extérieur).
Enfin, cette fiole possède un bouchon permettant de laisser passer l’oxygène, essentiel pour faire bouger la levure, tout en empêchant la contamination par d’autres bactéries.
Une fois l’opération réalisée, la fiole est placée dans un agitateur orbital pendant une nuit. Les « chicanes » que l’on retrouve sur les parois du récipient permettent de remuer le liquide tout en incorporant l’oxygène, accélérant ainsi la prolifération des cellules de levure.

Le lendemain matin, le liquide est devenu trouble, prouvant que la multiplication a bien eu lieu. (Dans le cas contraire, on aurait une sorte de « tâche d’huile » en surface de l’extrait de malt, indiquant que la levure reste en surface et ne se nourrit pas des nutriments mis à sa disposition… Et donc ne développe pas de colonies).

Magic Box
Le test de la boîte stérile est complémentaire au test de la fiole.
Toujours sous la hotte à flux d’air continu, on y étale un gel à base de agar-agar, permettant d’y fixer ensuite des nutriments. On incorpore un autre échantillon de « précipité ».
La levure se nourrit alors des nutriment, le liquide se solidifie et on voit apparaître des petites colonies dans la boîte.
La culture de la levure
Quand une colonie apparaît, les techniciens récupèrent un extrait et relancent une nouvelle culture, en utilisant les mêmes procédés expliqués ci-dessus (pour être sûr d’avoir un résultat pur). On extrait ensuite quelques cellules des nouvelles colonies, que l’on met dans des fioles avec du glycérol. Et hop ! Au frigo à -80°C ! Niveau conservation, y a pas mieux !

Dès que vous voulez brasser, ils sortent un petit échantillon de colonie, qu’ils font se multiplier. Vous recevez alors un joli échantillon de levure prêt à l’emploi.
Et après, y a plus qu’à !


